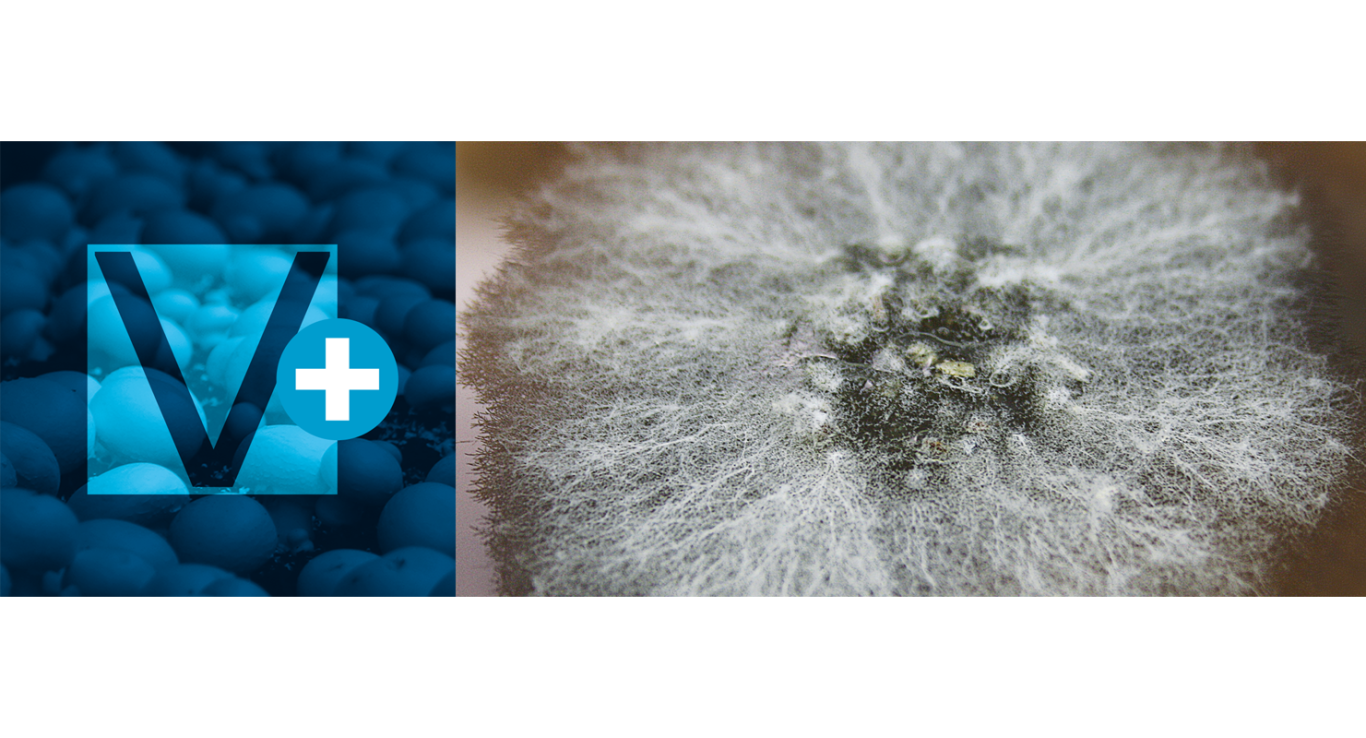

THE GERM IS NOTHING,
THE TERRAIN IS EVERYTHING
Louis PASTEUR
The highly specialised EuroMycel mushroom spawn fulfils the expectations of the fresh and mechanical harvest growers.
Our selection process is unique because the master cultures are sorted according to their specific interaction with compost.
OUR PHILOSOPHY
We assume that genetics of
Agaricus bisporus is definitively not the limiting factor for biotransformation…
CONSISTENCY
Our unique strain maintenance relying upon mycelium interaction with compost…
OUR PRESENCE
We supply millions of litres of spawn in several countries…

OUR EXPERTISES
Discover EuroMycel's expertise, unique production techniques and unconditional love of the product.
55, route de Chinon
La Croix Senard
37220 l’Île-Bouchard
France
Téléphone: + 33 247 970 355
E-mail: euromycel@euromycel.com